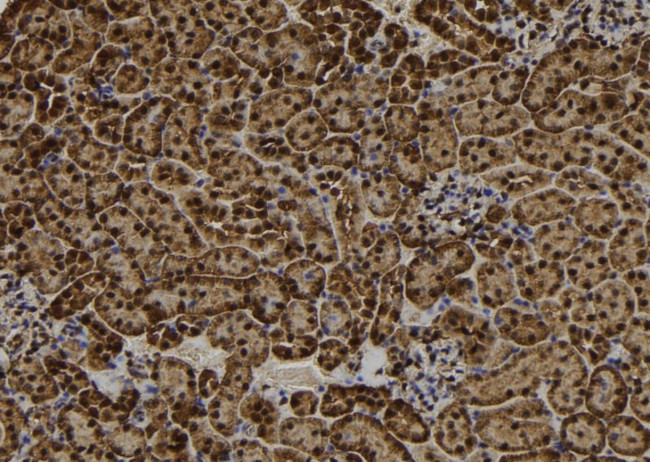
RAD18 Antibody in Immunohistochemistry (Paraffin) (IHC (P))

Search
Invitrogen
RAD18 Polyclonal Antibody
{{$productOrderCtrl.translations['antibody.pdp.commerceCard.promotion.promotions']}}
{{$productOrderCtrl.translations['antibody.pdp.commerceCard.promotion.viewpromo']}}
{{$productOrderCtrl.translations['antibody.pdp.commerceCard.promotion.promocode']}}: {{promo.promoCode}} {{promo.promoTitle}} {{promo.promoDescription}}. {{$productOrderCtrl.translations['antibody.pdp.commerceCard.promotion.learnmore']}}
图: 1 / 2
RAD18 Antibody (PA5-102756) in IHC (P)


Please note: We are reviewing Western blot images included in the antibody testing data in our catalog, including those provided by third parties. Unless expressly labeled or annotated as “raw-unedited”, Western blot images included in the antibody testing data in our catalog may have been edited, optimized or otherwise adjusted for presentation.
产品信息
PA5-102756
种属反应
宿主/亚型
分类
类型
抗原
偶联物
形式
浓度
规格
纯化类型
保存液
内含物
保存条件
运输条件
RRID
产品详细信息
Antibody detects endogenous levels of total RAD18.
靶标信息
Human Rad18 (hRad18) is homologue of the S. pombe Rad18 (3,4). In yeast, Rad6 and Rad18 play a crucial role in post-replication repair functions in gap-filling of a daughter strand on replication of damaged DNA (2). Furthermore, Rad6-Rad18 interaction is thought to be critical at an early step during lesion bypass in yeast. In vivo, Rad18 protein forms a tight complex with Rad6 through a conserved ring-finger motif (3,4). It has been suggested that Rad18-Rad6 complex binds to the damaged sites by the single-stranded DNA binding property of Rad 18. This is followed by degradation of the stalled components of DNA replication by ubiquitin-conjugating enzyme activity of Rad6 (1). The human Rad18 maps on chromosome 3p24-25, the region which is often deleted in lung, breast, ovary, and testis cancers. The human RAD18 gene codes for a protein of 495 amino acids with a predicted molecular weight of 56 kDa. The human Rad18 is ubiquitously expressed in various human tissues.
仅用于科研。不用于诊断过程。未经明确授权不得转售。
篇参考文献 (0)
生物信息学
蛋白别名: E3 ubiquitin-protein ligase RAD18; hHR18; mRAD18Sc; post-replication repair protein RAD18SC; Postreplication repair protein RAD18; RAD18 homolog; RING finger protein 73; RING-type E3 ubiquitin transferase RAD18
基因别名: 2810024C04Rik; RAD18; Rad18sc; RNF73
UniProt ID: (Mouse) Q9QXK2
Entrez Gene ID: (Mouse) 58186, (Rat) 362412